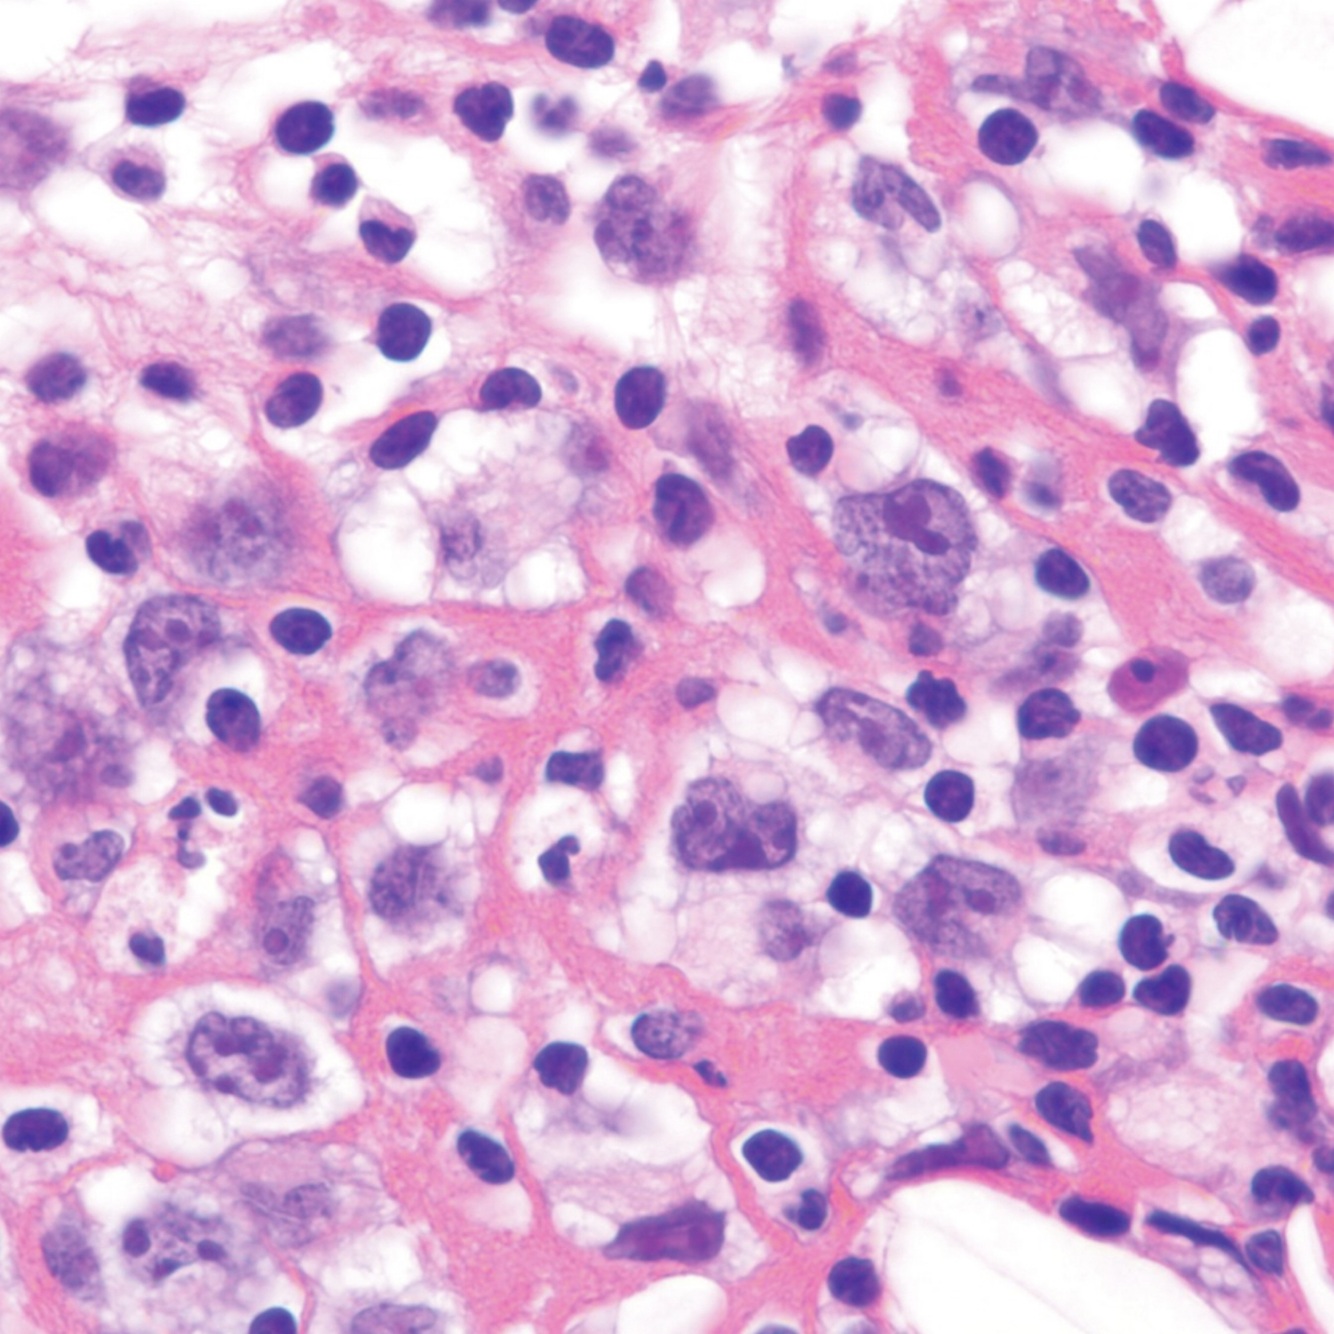

1
Q
57F breast

A
Solid papillary CA
2
Q
62F breast

A
Encapsulated papillary CA
3
Q
53F breast effusion cell block
Hx breast CA and reconstruction

A
Breast implant associated anaplastic large cell lymphoma
57F breast

Solid papillary CA
62F breast

Encapsulated papillary CA
53F breast effusion cell block
Hx breast CA and reconstruction
Breast implant associated anaplastic large cell lymphoma